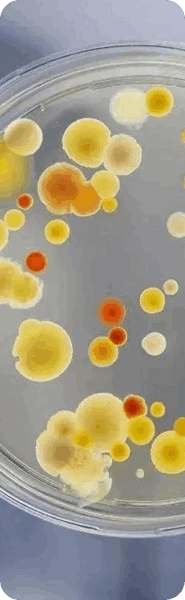
application in Microbial Fermentation

LABOAO offer scalable from 0.1mL to 15KL of bioreactors & fermenters made in single-use or glass, stainless steel to cater the optimum growth of cells or tissues in microbial and cell culture.
Get Your Solution







LABOAO has many years of experience focusing on the biopharmaceutical and bioengineering industries and its production services. We provide bioreactors ranging in size from 0.1L to 1000KL bioreactor fermenter. We can produce lab glass bioreactor, parallel glass bioreactor, stainless steel bioreactor, solid state bioreactor, photobioreactor, single-use bioreactor, GMP fermenter system, CIP/SIP bioreactor system.
Get Your Solution


Qualified Manufacturing With Quality Certifications
LABOAO offer scalable from 0.1mL to 15KL of bioreactors & fermenters made in single-use or glass, stainless steel to cater the optimum growth of cells or tissues in microblal and cell culture.

Copyright @ 2024 LABOAO All Right Reserved
sales@laboao.com 0086 18539927482
No.109 Bitao Road, Hi-Tech Development Zone, Zhengzhou, China